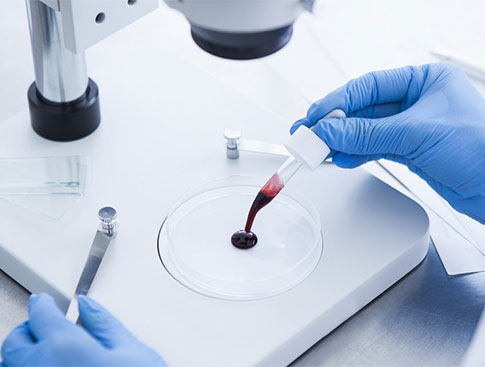

Un liquide biologique (ou liquide organique ou fluide corporel) désigne de manière générale un liquide produit par un organisme vivant.
Liquide au sein d'un circuit ou d'une cavité fermés
Liquide circulant
• sang (environ cinq litres) contenu dans l'appareil circulatoire (veines, capillaires, artères, cœur)
• lymphe (quantité variable, environ huit litres) et le chyle dans le système lymphatique
Liquide non circulant
• le liquide cérébrospinal (environ 150 mL) contenu dans la boîte crânienne et le canal rachidien,
baignant le système nerveux central et les racines des nerfs
• le liquide synovial à l'intérieur des capsules articulaires, des bourses séreuses et des gaines
synoviales
• le liquide pleural dans la cavité pleurale autour de chacun des deux poumons
• le liquide péritonéal dans la cavité péritonéale autour des intestins
• le liquide péricardique dans la cavité péricardique autour du cœur
• la moelle osseuse dans le sternum, l'os iliaque ou les os longs (dans l'enfance)
• l'humeur aqueuse dans la chambre antérieure de chacun des deux yeux
• la périlymphe dans le labyrinthe osseux et baignant le labyinthe membraneux de chaque oreille
interne
• l'endolymphe dans le labyrinthe membraneux de chaque oreille interne
• le liquide amniotique (jusqu'à 800 mL à 28 semaines d'âge gestationnel) dans l'utérus autour de
l'embryon ou du fœtus au cours de la grossesse chez la femme
• le liquide contenu dans les cavités embryonnaires transitoires que sont le blastocèle, la vésicule
vitelline primitive et la cavité choriale
Liquide dans un circuit ouvert
Liquide avec un système spécifique
• l'urine (environ 1,5 litres par jour) produite par les deux reins et stockée dans la vessie (300 mL).
• la salive (environ 1 litre par jour) produite par les glandes salivaires (parotides, submandibulaires
et sublinguales essentiellement).
• le suc gastrique (environ 2 litres par jour) produit par l'estomac.
• la bile (environ 1 litre par jour) produite par le foie et stockée dans la vésicule biliaire (50 mL).
• le suc pancréatique (environ 1 litre par jour) produit par le pancréas.
• les larmes produites par les glandes lacrymales.
• le sperme issu de la réunion des liquides des vésicules séminales et de la prostate chez l'homme.
• le lait (jusqu'à 800 mL par jour) produit par chaque glande mammaire au cours des périodes
d'allaitement chez la femme.
Parmi ces liquides, ceux qui sont excrétés sont l'urine, le sperme et le lait.
Liquide sans système spécifique
• a sueur (débit variable : 100 mL à 8 litres par jour) produite par les glandes sudoripares de la peau
• les expectorations issues des sécrétions des muqueuses des voies respiratoires basses (trachée et bronches)
• le mucus, désignant toute sécrétion des muqueuses digestives, respiratoires et génitales
• les chassies, sécrétées par les yeux pendant le sommeil
Les liquides excrétés sont la sueur et les expectorations.
Liquide pathologique
Le pus ou la sérosité désignent des liquides pathologiques qui peuvent être :
• sécrétés
• accumulés dans une cavité physiologique (comme celles que nous avons vu plus haut, ou par exemple
une oreille moyenne ou un sinus paranasal)
• accumulés dans une cavité pathologique (qu'on nomme alors abcès)
Au niveau de la peau et des muqueuses, on appelle pustule une structure contenant du pus, et vésicule ou
bulle une structure contenant une sérosité.
Analyse des liquides
Pour les liquides qui sont excrétés un simple recueil suffit : urine, sueur, lait, sperme, expectoration.
• prélèvement urétral
• prélèvement vaginal
• urines de premier jet
• urines de second jet
Pour les liquides cavitaires, on doit procéder à une méthode de ponction adéquate :
- Sang :
• ponction veineuse ou phlébotomie ("prise de sang" dans le langage courant),
le plus souvent au niveau de la veine céphalique, basilique ou médiane d'un avant-bras, ou d'une
veine dorsale d'une main
• ponction artérielle, le plus souvent au niveau de l'artère ulnaire ou radiale d'un avant-bras
• ponction capillaire, le plus souvent au niveau de la face latérale du segment distal d'un doigt
• liquide cérébrospinal : ponction lombaire
• liquide synovial : ponction articulaire, le plus souvent au niveau d'un genou
• moelle osseuse : ponction médullaire
• liquide pleural : ponction pleurale
• liquide péritonéal : ponction d'ascite
• liquide amniotique : amniocentèse
• liquide d'oreille moyenne : paracentèse
Les ponctions sanguines sont en principe effectuées par un infirmier, les autres par un médecin.
Type d'analyse
La spécialité médicale chargée d'étudier ces liquides est la biologie médicale. Ces liquides peuvent être
étudiés selon plusieurs angles :
• la biochimie va en étudier les molécules avec l'hormonologie pour les hormones et la toxicologie pour les
médicaments et toxiques,
• la cytologie pathologique va en étudier les cellules pathologiques,
• l'hématologie va étudier le sang donc les cellules sanguines et l'hémostase,
• l'immunologie va étudier le système immunitaire,
• la génétique va en étudier le génome,
• la microbiologie médicale va chercher à en étudier les microbes (bactéries et virus),
• la parasitologie médicale va en chercher à en étudier les parasites.
Les analyses sont effectuées par un technicien de laboratoire sous la responsabilité d'un biologiste médical.